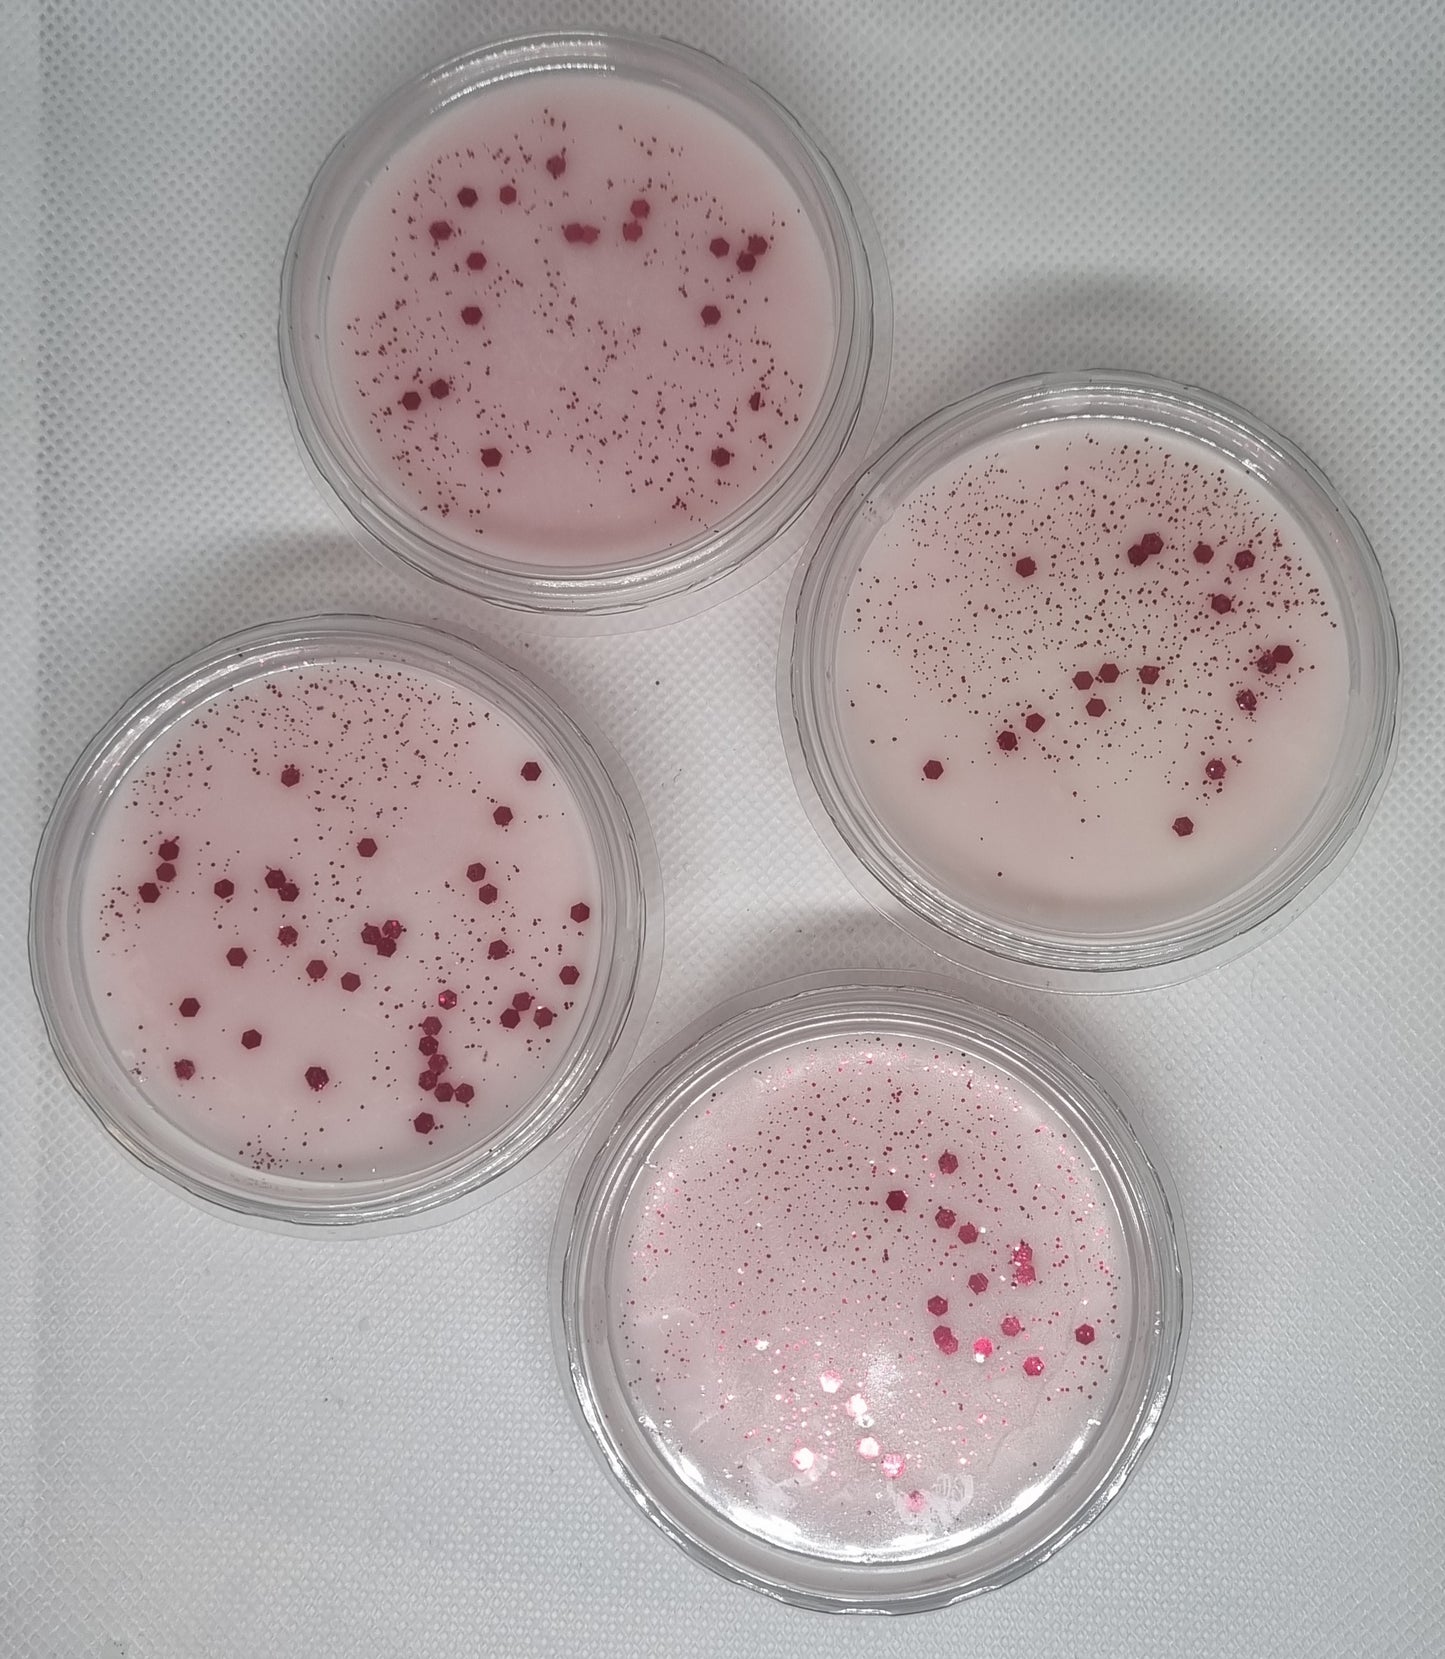

Loving SCENTiments
2oz pot wax melt
2oz pot wax melt
Methu â llwytho argaeledd casglu
Hand Poured Wax Melt
Indulge in the luxurious scents of our hand-poured wax melt. Each bar can be broken up into pieces for multiple uses and comes with a CLP sticker on the reverse side for safety. With a variety of different scents to choose from, you can enjoy up to 8 hours of burn time with each piece.
Sugared cuddles
Embrace this rich and luxurious fragrance where edible notes of creamy vanilla and indulgent toffee mingle with uplifting tones of orange and coconut. Sweet and honeyed guaiac wood leads to a soothing bed of amber, musk and sandalwood, layered with a sprinkling of sugar
Caring freshness & rose petals
Lemon sherbert
A stunning cross between ice cream and sorbet with a super sweet tangy lemon scent.
Yummy mummy
Mummy by name, yummy by nature! Bursting with lush fruits, this scent opens with exotic mango, passionfruit, fresh juicy pineapple and pink grapefruit. A heart of jasmine blossoms is followed by a mouth-watering base of raspberry sorbet.
Mama bear
A bold fragrance for the fierce and strong women in our lives! Juicy notes of mango and bergamot meet a feminine heart of jasmine, before smooth sandalwood and warm vanilla finish off this confident and inspiring accord.
Grandma`s kitchen
Transport yourself to Grandma’s kitchen, where love is served daily. A delicious spread of sweet cakes and biscuits in which soft citrus top notes meet creamy almond and coconut. A heart with edible nuances of meringue rests on a yummy base of vanilla, tonka bean and a sprinkling of crystallised sugar.
Captive
A rich floral but fruity accord with notes of pink pepper, mandarin and bergamot infused with lashings of peach, blackcurrant, patchouli and amber for a rich blend.
Sunday cuddles
The jobs are done and there’s nothing to rush about for, as you enjoy some Sunday Cuddles with the family. This cosy oriental accord reveals citrus facets, followed by soft peach and a hint of coconut. The floral heart emerges through heliotrope, jasmine, lily and rose, descending onto a sumptuous base of sandalwood, cocoa, amber, musk and creamy vanilla.
Got it from my mama
Sassy and sweet, just how mama raised ya! Fruity notes of soft peach, lush raspberry, red fruits and pomegranate are elevated by a floral heart of precious rose, lily, jasmine, peony and violet. This fabulous blend is brought to a close by amber, sandalwood and vanilla with a sprinkling of sugar, for a scent that exudes goddess energy!
Brightest star
A feminine aromatic floral blend of pink petals with fresh mint leaves laid on a bed of fresh fruit.
Cocoa fleur
A rich fusion of pink pepper and violet leaf, which meets a middle layer of floral notes from jasmine, rose and patchouli. A crisp base of cedarwood, sandalwood, iris, musk and amber makes this a popular fresh accord.
Cosy cabin
Enjoy the tranquillity of the cosy cabin with a woody yet sweet cedarwood top note that is complemented by creamy vanilla, smooth sandalwood and incense. A delicate touch of patchouli adds an elegant twist and depth that is pleasantly unexpected.
Black cat crossing
Don’t be such a scaredy cat! Dare to embrace this intense harmony of cool bergamot and spicy pepper, enriched by a full blooming heart of rose and saffron. On dry down, a dark sultry blend of musk, amber and oudh creates a lingering trail.
Caring freshness & golden honey
A stunning house blend of our notorious caring freshness (A fresh laundry aroma with lingering notes of rich almond milk and golden manuka honey). Blended with a fountain of extra honey for a golden version of the OG that has zero trace of sass and just lashings of sweetness!
Desirable
A strong yet fresh composition of fresh orange to awaken the senses that rests on a bed of jasmine and rose. Patchouli and vetiver give the heart of this scent a serene elegance
Pearly gates
A scent that exudes freshness and sensuality. Waves of fresh bergamot and ground pink pepper open the scent before reaching the beautifully blended heart of praline and dewy red berries. The base is a strong bed of white musk, cedar wood and patchouli topped with a slight dash of vanilla to add the perfect amount of angelic sweetness.
Goody 2-shoes
An alluring accord with rich cocoa and jasmine floats around notes of tonka bean and almond for an audacious finish.
Fairy flutter
An intoxicating vanilla fragrance with notes of white orchid and sparkling sugar warmed by jasmine, tonka, coconut, vanilla, cocoa bean and creamy sandalwood.
Pal radiant glow
A rich fragrance which blends coconut with raspberry, cherry blossom, peach and milky vanilla.
Baby Powder
A powdery warm floral combination of rose, Jasmine and geranium, containing powdery aldehydic back notes.
Rhannu